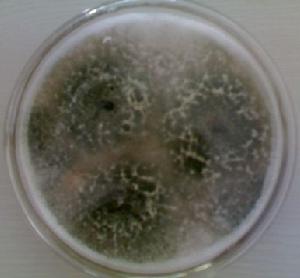
木黴菌生物農藥

木黴菌生物農藥
木黴菌生物農藥系新型生物殺菌劑。通過產生抗生素、營養競爭、微寄生、細胞壁分解酵素、以及誘導植物產生抗性等機制,對於多種植物病原菌具有拮抗作用,具有保護和治療雙重功效,可有效防治土傳性真菌病害,在苗床使用木黴菌劑,可提高育苗與移植的成活率,保持秧苗健壯生長。也可用於防治灰霉病。
本品特效期長,作用位點多,不產生抗藥性,突破常規殺菌劑受限條件,不怕高濕,而且濕度越大防治效果越好。殺菌譜廣,無殘留毒性,對作物沒有任何不良影響。
【含 量】有效活菌數≥10cfu/g
【成 分】活體孢子
【性 狀】粉劑,可溶
認識木黴菌和生物農藥
木黴菌木黴菌(Trichoderma),是一類普遍存在的真菌,廣泛分布於土壤、空氣、枯枝落葉及
木黴菌圖片
木黴菌圖片生物農藥是指利用生物活體或其代謝產物對害蟲、病菌、雜草、線蟲、鼠類等;生物農藥是有害生物進行防治的一類農藥製劑,或者是通過仿生合成具有特異作用的農藥製劑。關於生物農藥的範疇,目前國內外尚無十分準確統一的界定。按照聯合國糧農組織的標準,生物農藥一般是天然化合物或遺傳基因修飾劑,主要包括生物化學農藥(信息素、激素、植物調節劑、昆蟲生長調節劑)和微生物農藥(真菌、細菌、昆蟲病毒、原生動物,或經遺傳改造的微生物)兩個部分,農用抗生素製劑不包括在內。我國生物農藥按照其成分和來源可分為微生物活體農藥、微生物代謝產物農藥、植物源農藥、動物源農藥四個部分。按照防治對象可分為殺蟲劑、殺菌劑、除草劑、殺蟎劑、殺鼠劑、植物生長調節劑等。就其利用對象而言,生物農藥一般分為直接利用生物活體和利用源於生物的生理活性物質兩大類,前者包括細菌、真菌、線蟲、病毒及拮抗微生物等,後者包括農用抗生素、植物生長調節劑、性信息素、攝食抑制劑、保幼激素和源於植物的生理活性物質等。但是,在我國農業生產實際套用中,生物農藥一般主要泛指可以進行大規模工業化生產的微生物源農藥。
木黴菌生物防治套用
木黴菌可抑制多種植物真菌(至目前報導約29種真菌)病,研究最多的真菌是根腐病、立枯病、猝倒病、枯萎病等土傳病害、灰黴菌、腐黴菌、絲核菌、炭疽菌、鐮刀菌、菌核病。木黴菌使用於拌土、拌種、注射及噴灑,經實驗能減少土壤中病原真菌的密度,並降低病害的發生。
 木黴菌生物農藥圖片
木黴菌生物農藥圖片木黴菌使用方式
木黴菌依不同作物種類與作物不同時期有不同的使用方式,主要是要讓木黴菌均勻分布於植物根部、表面與土壤中,短期作物使用1-2次,果樹花卉等多年生作物每年使用3-4次即可,木黴菌使用次數越多效果越明顯,長期使用可有效減少土壤傳播性病害發生,多用有益無害。木黴菌使用時常添加米糠或豆粕以增加田間木黴菌增殖的能量也方便木黴菌在田間的分散性,使用量約為木黴菌之20-40倍。
| 作物種類 | 使用方式 | 建議用量 | 施用方式 |
| 水稻 | 分櫱盛期與抽穗期各使用一次 | 每分地/0.5kg | 噴灑 |
| 葉菜類 | 播種(或種苗)及葉片交疊初期各使用一次 | 每分地/2kg | 噴灑、灌注、混拌、堆肥 |
| 花卉及觀葉植物 | 每月使用一次,連續3次 | 每分地/2kg | 噴灑、灌注、堆肥 |
| 茄科或小黃瓜 | 每月使用一次,連續3次 | 1000株/1kg | 噴灑、灌注、混拌、堆肥 |
| 苦瓜與絲瓜 | 每月使用一次,連續3次 | 200株/1kg | 噴灑、灌注、混拌、堆肥 |
| 檳榔 | 每月使用一次,連續3次 | 1000株/1kg | 噴灑、灌注、混拌、堆肥 |
| 果樹 | 每月使用一次,連續3次 | 100株/1kg | 噴灑、灌注、混拌、堆肥 |
| 草皮 | 每月使用一次,連續3次 | 每分地/2kg | 噴灑、灌注、混拌、堆肥 |
| 球根與塊莖類 | 每月使用一次,連續3次 | 種塊1000kg/1kg | 浸泡、噴灑、灌注、混拌、堆肥 |
| 草莓 | 每月使用一次,連續3次 | 2000株/1kg | 噴灑、灌注、混拌、堆肥 |
種子拌種:每公斤種子直接混合100克木霉菌粉劑用於直播(種子先浸水並馬上甩去多餘水份並添加木黴菌粉劑混合後直播)。
種苗、種薯與塊莖處理:
插穗:插穗以木黴菌300-500倍稀釋液浸泡後直接扦插。
苗栽:以木黴菌300-500倍稀釋液整株浸泡後直接種植。
球根與塊莖:以木黴菌300-500倍稀釋浸泡種後直接種植。
表面噴灑
葉部噴灑:請以木黴菌粉劑500-1000倍噴施。
土壤或有機質肥料表面:請以木黴菌粉劑500-1000倍噴施於有機質或土壤表面。
介質與土壤處理
(一)混拌:
方法(1)
1、1份的木黴菌粉劑添加20份的米糠混合均勻(放大使用)。
2、將1000份的介質(或有機質肥料)與上述材料再次混合併添加少量的水(維持少量濕度)。
3、露天堆放7天可使用(不可以用不透氣的袋子覆蓋以免產生阿摩尼亞毒害木黴菌)。
方法(2)
1、1份的木黴菌粉粒劑添加於200-500份的介質(或有機質肥料)混合均勻。
2、直接用於育苗或田間。
(二)灌註:以木黴菌粉劑500-1000倍灌注於土中或介質中。
